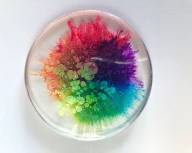

/ Торговая площадка
/ Прочее
/ Прочее
Продукция на продажу: Прочее ,
Дата подачи заявки: 27.03.2022
ID: 155216,
Область: Днепропетровская область,
Район: Днепропетровский
Товар: Прочее ,
Количество: 1 т.
Цена: договорная
эпоксидная смола
"ООО ""УКРСТАРЛАЙН"" реализует широкий ассортимент металлопроката: черного, оцинкованного, нержавеющего, цветного, а также - резинотехнической продукции по выгодным ценам.
Доставка осуществляется быстро по всей Украине.
Имеем возможность завозить под заказ или производить интересующие клиента позиции.
Заявки сбрасывайте на вайбер (оператор киевстар).
Наши профессиональные менеджеры с радостью проконсультируют каждого клиента.
Эпоксидная смола оптически прозрачный не желтеющий низковязкий двухкомпанентный компаунд холодного отверждения на эпоксидной основе. Применение: изготовление прозрачных композиций, полимерных полов типа «3D», а так же как связующее для цветного песка и для запечатки покрытия типа «песчаный ковёр». Время образования: 60 мин Твёрдость по Шору Д: 76 Соотношение на 100 грамм смолы 40 грамм отвердителя. Гарантийный срок хранения 12 месяцев Упаковка: от 0.7 кг
"
Телефон:
email:
Контактное лицо: Укрстарлайн
Другое. Торговая площадка Украины
Продукция на продажу: Прочее ,
Дата подачи заявки: 27.03.2022
ID: 155216,
Область: Днепропетровская область,
Район: Днепропетровский
Товар: Прочее ,
Количество: 1 т.
Цена: договорная
эпоксидная смола
"ООО ""УКРСТАРЛАЙН"" реализует широкий ассортимент металлопроката: черного, оцинкованного, нержавеющего, цветного, а также - резинотехнической продукции по выгодным ценам.
Доставка осуществляется быстро по всей Украине.
Имеем возможность завозить под заказ или производить интересующие клиента позиции.
Заявки сбрасывайте на вайбер (оператор киевстар).
Наши профессиональные менеджеры с радостью проконсультируют каждого клиента.
Эпоксидная смола оптически прозрачный не желтеющий низковязкий двухкомпанентный компаунд холодного отверждения на эпоксидной основе. Применение: изготовление прозрачных композиций, полимерных полов типа «3D», а так же как связующее для цветного песка и для запечатки покрытия типа «песчаный ковёр». Время образования: 60 мин Твёрдость по Шору Д: 76 Соотношение на 100 грамм смолы 40 грамм отвердителя. Гарантийный срок хранения 12 месяцев Упаковка: от 0.7 кг
"
Телефон:
email:
Контактное лицо: Укрстарлайн
Смотреть все обявления в разделе Прочее